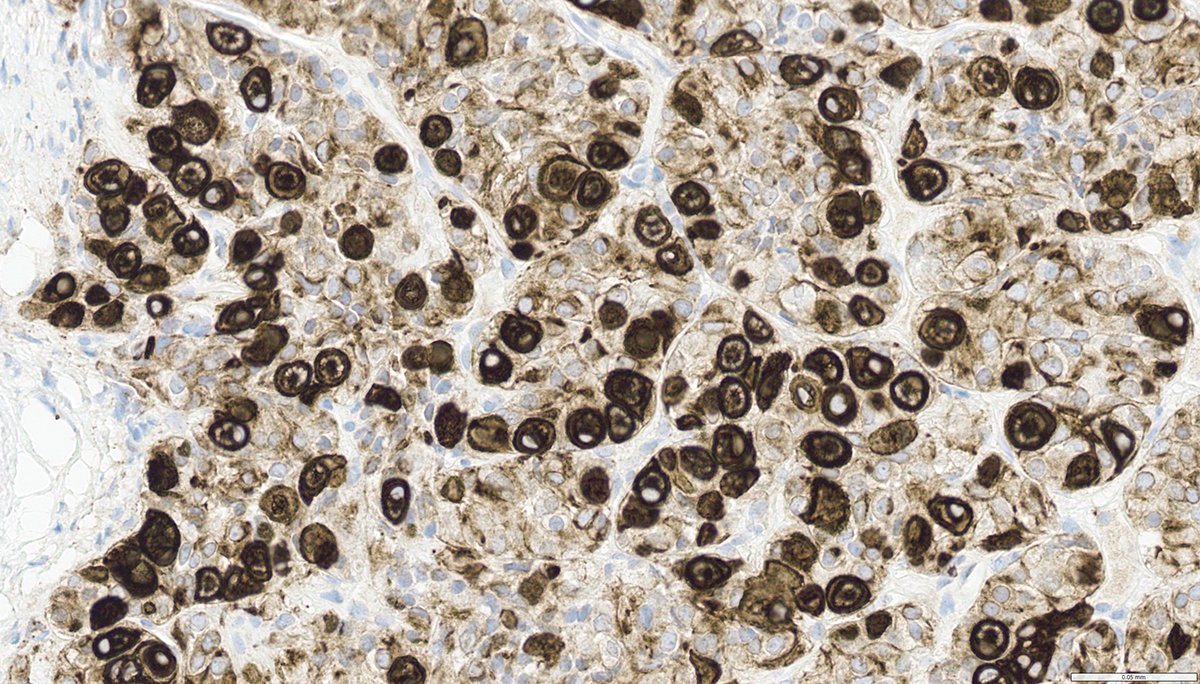
Craig Horbinski tweet media

Dan Graham
6.6K posts

Dan Graham
@DanGrahamMD
General Pathologist at Clinical Labs of Hawaii / Interest in BST & H&N
Straub Hosp, Honolulu, HI, USA Katılım Haziran 2009
1.2K Takip Edilen2.5K Takipçiler

@DanGrahamMD Hi Dan, long time no see. 🌸 cool morphology, I want a panel: Ck , desmin , cd117, S100, epithelioid pink cells with some spindle area. 😬
English

@DanGrahamMD Tumor with epithelioid and spindly areas. Fairly uniform. Vascular markers-ERG, CD 34, CD 31, Stat 6.
English

@DanGrahamMD Monomorphic round to spindle cells proliferation, suggestive of aggressive systemic mastocytosis versus mast cell leukemia. Need CD117 , CD30, Giemsa and mast cell tryptase if available.
English


60s F w/ hyperparathyroidism. parathyroid nodule. Dx?
#EndocrinePath #HeadandNeckPath #PathX #PathTwitter




Eesti

Thanks!
Ankur Sangoi@slusagar
@DanGrahamMD great Q! No minimum quant per say I report any %, as long as it is def chorio (syncytios+admixed cytotrophs; often assoc w/hemm). fortunately, per this paper limited chorio (<5%) likely not prognostic anyhow, but for completeness and to correlate with serum HCG I report any
English

@slusagar I think I’ve made that mistake of calling a chorio component. So now we gotta know, what’s the minimum required to call it?
English

#GUpath orchiectomy:
mixed germ cell tumor (GCT) with admixed syncytiotrophoblasts
✔️may account for low serum elevations of HCG but NOT diagnostic of choriocarcinoma elements




English


@slusagar @katcollmd @StanfordPath My head is in the gutter. Thinking of popcorn worse lung w/ diacetyl lol
English

Dermatofibroma
Like the dry soil of the Caatinga (a Brazilian biome), the collagen appears trapped at the periphery 😬
#path #pathology #dermatology #art


English

@CraigHorbinski @NamrataMaity Beautiful one Craig. I remember you showing another case like it a while back, which was how I learned about it in the first place!
English
Dan Graham retweetledi

This is as good an example of Crooke hyaline change as you'll ever see, from a patient with Cushing's disease. Note the concentric rings on CAM 5.2. #pathology #neuropath #PathTwitter

English
Dan Graham retweetledi























